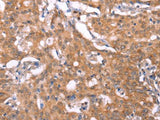
FBXO31 Polyclonal Antibody Store at -20°C Host Rabbit

FBXO31 Polyclonal Antibody Store at -20°C Host Rabbit
SKU: E-AB-16428-200
FBXO31 Polyclonal Antibody Store at -20°C Host Rabbit
| SKU # | E-AB-16428 |
| Reactivity | Human, Mouse, Rat |
| Host | Rabbit |
| Applications | IHC |
Product Details
| Isotype | IgG |
| Host | Rabbit |
| Reactivity | Human, Mouse, Rat |
| Applications | IHC |
| Clonality | Polyclonal |
| Immunogen | Synthetic peptide of human FBXO31 |
| Abbre | FBXO31 |
| Synonyms | DKFZp434B027, DKFZp434J1815, F box only protein 31, F box protein 31, F-box only protein 31, FBX14, FBX31, FBXO14, FLJ22477, Fbxo31, MGC15419, MGC9527, Putative breast cancer tumor suppressor, SCF ubiquitin ligase specificity factor, pp2386 |
| Swissprot | |
| Cellular Localization | Cytoskeleton, centrosome, Cytosol, Other locations: neuronal cell body, SCF ubiquitin ligase complex. |
| Concentration | 0.7 mg/mL |
| Buffer | Phosphate buffered solution, pH 7.4, containing 0.05% stabilizer and 50% glycerol. |
| Purification Method | Affinity purification |
| Research Areas | Cancer, Cell biology |
| Conjugation | Unconjugated |
| Storage | Store at -20°C Valid for 12 months. Avoid freeze / thaw cycles. |
| Shipping | The product is shipped with ice pack,upon receipt,store it immediately at the temperature recommended. |
Related Reagents
| Applications | Recommended Dilution |
| IHC | 1:50-1:200 |
Background
This gene is a member of the F-box family. Members are classified into three classes according to the substrate interaction domain, FBW for WD40 repeats, FBL for leucing-rich repeats, and FBXO for other domains. This protein, classified into the last category because of the lack of a recognizable substrate binding domain, has been proposed to be a component of the SCF ubiquitination complex. It is thought to bind and recruit substrate for ubiquitination and degradation. This protein may have a role in regulating the cell cycle as well as dendrite growth and neuronal migration. Alternative splicing results in multiple transcript variants.